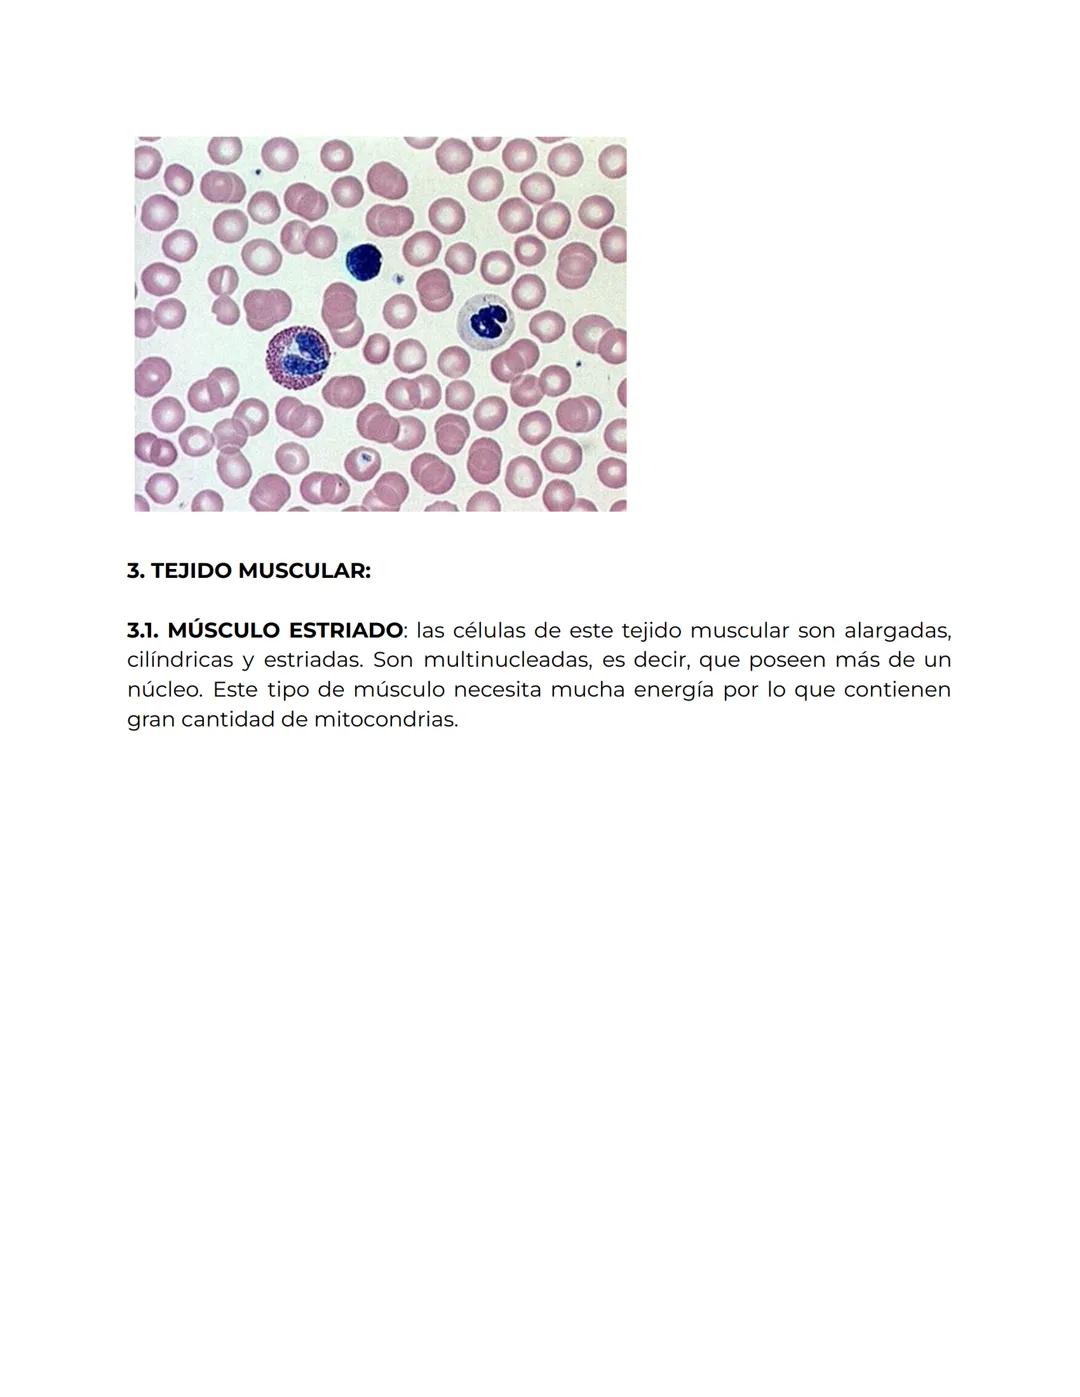

tipos de tejidos
Inscríbete para ver los apuntes¡Es gratis!
Acceso a todos los documentos
Mejora tus notas
Únete a millones de estudiantes
Al registrarte aceptas las Condiciones del servicio y la Política de privacidad.
El sistema nervioso
Ecología y medio ambiente
La dinámica y composición terrestre
Aparato excretor
Los microorganismos
Fisiología e histología vegetal
Alimentos y nutrientes
La evolución de la vida
Nutrición: aparato digestivo y respiratorio
Estructura y organización del cuerpo humano
Los microorganismos y formas acelulares
La dinámica de la tierra
Fisiología e histología animal
El modelado de la superficie terrestre
El aparato circulatorio
Mostrar todos los temas
El imperio bizantino y el imperio carolingio
La civilización griega.
Los conflictos en españa (1902-1939)
La era de las revoluciones liberales
La revolución industrial
El siglo xviii en europa hasta 1792
El siglo xviii en europa hasta 1790
El mundo en el periodo de entreguerras
Estructura y sociedad urbana
El feudalismo en europa
Causas y las consecuencias de la segunda guerra mundial (1939-1945) y el holocausto
La prehistoria
La primera guerra mundial
La guerra fría y descolonización de asia y áfrica
Principales acontecimientos históricos en la península ibérica del siglo viii al siglo xii).
Mostrar todos los temas

87
1
stef veiz
26/10/2025
Biología y Geología
tipos de tejidos
1569
•
26 oct 2025
•
stef veiz
@estef_veizz
tipos de tejidos




















Nuestro compañero de IA está específicamente adaptado a las necesidades de los estudiantes. Basándonos en los millones de contenidos que tenemos en la plataforma, podemos dar a los estudiantes respuestas realmente significativas y relevantes. Pero no se trata solo de respuestas, el compañero también guía a los estudiantes a través de sus retos de aprendizaje diarios, con planes de aprendizaje personalizados, cuestionarios o contenidos en el chat y una personalización del 100% basada en las habilidades y el desarrollo de los estudiantes.
Puedes descargar la app en Google Play Store y Apple App Store.
Sí, tienes acceso gratuito a los contenidos de la aplicación y a nuestro compañero de IA. Para desbloquear determinadas funciones de la aplicación, puedes adquirir Knowunity Pro.
App Store
Google Play
La app es muy fácil de usar y está muy bien diseñada. Hasta ahora he encontrado todo lo que estaba buscando y he podido aprender mucho de las presentaciones. Definitivamente utilizaré la aplicación para un examen de clase. Y, por supuesto, también me sirve mucho de inspiración.
Pablo
usuario de iOS
Esta app es realmente genial. Hay tantos apuntes de clase y ayuda [...]. Tengo problemas con matemáticas, por ejemplo, y la aplicación tiene muchas opciones de ayuda. Gracias a Knowunity, he mejorado en mates. Se la recomiendo a todo el mundo.
Elena
usuaria de Android
Vaya, estoy realmente sorprendida. Acabo de probar la app porque la he visto anunciada muchas veces y me he quedado absolutamente alucinada. Esta app es LA AYUDA que quieres para el insti y, sobre todo, ofrece muchísimas cosas, como ejercicios y hojas informativas, que a mí personalmente me han sido MUY útiles.
Ana
usuaria de iOS
Está app es muy buena, tiene apuntes que son de mucha ayuda y su IA es fantástica, te explica a la perfección y muy fácil de entender lo que necesites, te ayuda con los deberes, te hace esquemas... en definitiva es una muy buena opción!
Sophia
usuario de Android
Me encanta!!! Me resuelve todo con detalle y me da la explicación correcta. Tiene un montón de funciones, ami me ha ido genial!! Os la recomiendo!!!
Marta
usuaria de Android
La uso casi diariamente, sirve para todas las asignaturas. Yo, por ejemplo la utilizo más en inglés porque se me da bastante mal, ¡Todas las respuestas están correctas! Consta con personas reales que suben sus apuntes y IA para que puedas hacer los deberes muchísimo más fácil, la recomiendo.
Izan
usuario de iOS
¡La app es buenísima! Sólo tengo que introducir el tema en la barra de búsqueda y recibo la respuesta muy rápido. No tengo que ver 10 vídeos de YouTube para entender algo, así que me ahorro tiempo. ¡Muy recomendable!
Sara
usuaria de Android
En el instituto era muy malo en matemáticas, pero gracias a la app, ahora saco mejores notas. Os agradezco mucho que hayáis creado la aplicación.
Roberto
usuario de Android
Esto no es como Chatgpt, es MUCHISMO MEJOR, te hace unos resúmenes espectaculares y gracias a esta app pase de sacar 5-6 a sacar 8-9.
Julyana
usuaria de Android
Es la mejor aplicación del mundo, la uso para revisar los deberes a mi hijo.
Javier
usuario de Android
Sinceramente me ha salvado los estudios. Recomiendo la aplicación 100%.
Erick
usuario de Android
Me me encanta esta app, todo lo que tiene es de calidad ya que antes de ser publicado es revisado por un equipo de profesionales. Me ha ido genial esta aplicación ya que gracias a ella puedo estudiar mucho mejor, sin tener que agobiarme porque mi profesor no ha hecho teoría o porque no entiendo su teoría. Le doy un 10 de 10!
Mar
usuaria de iOS
La app es muy fácil de usar y está muy bien diseñada. Hasta ahora he encontrado todo lo que estaba buscando y he podido aprender mucho de las presentaciones. Definitivamente utilizaré la aplicación para un examen de clase. Y, por supuesto, también me sirve mucho de inspiración.
Pablo
usuario de iOS
Esta app es realmente genial. Hay tantos apuntes de clase y ayuda [...]. Tengo problemas con matemáticas, por ejemplo, y la aplicación tiene muchas opciones de ayuda. Gracias a Knowunity, he mejorado en mates. Se la recomiendo a todo el mundo.
Elena
usuaria de Android
Vaya, estoy realmente sorprendida. Acabo de probar la app porque la he visto anunciada muchas veces y me he quedado absolutamente alucinada. Esta app es LA AYUDA que quieres para el insti y, sobre todo, ofrece muchísimas cosas, como ejercicios y hojas informativas, que a mí personalmente me han sido MUY útiles.
Ana
usuaria de iOS
Está app es muy buena, tiene apuntes que son de mucha ayuda y su IA es fantástica, te explica a la perfección y muy fácil de entender lo que necesites, te ayuda con los deberes, te hace esquemas... en definitiva es una muy buena opción!
Sophia
usuario de Android
Me encanta!!! Me resuelve todo con detalle y me da la explicación correcta. Tiene un montón de funciones, ami me ha ido genial!! Os la recomiendo!!!
Marta
usuaria de Android
La uso casi diariamente, sirve para todas las asignaturas. Yo, por ejemplo la utilizo más en inglés porque se me da bastante mal, ¡Todas las respuestas están correctas! Consta con personas reales que suben sus apuntes y IA para que puedas hacer los deberes muchísimo más fácil, la recomiendo.
Izan
usuario de iOS
¡La app es buenísima! Sólo tengo que introducir el tema en la barra de búsqueda y recibo la respuesta muy rápido. No tengo que ver 10 vídeos de YouTube para entender algo, así que me ahorro tiempo. ¡Muy recomendable!
Sara
usuaria de Android
En el instituto era muy malo en matemáticas, pero gracias a la app, ahora saco mejores notas. Os agradezco mucho que hayáis creado la aplicación.
Roberto
usuario de Android
Esto no es como Chatgpt, es MUCHISMO MEJOR, te hace unos resúmenes espectaculares y gracias a esta app pase de sacar 5-6 a sacar 8-9.
Julyana
usuaria de Android
Es la mejor aplicación del mundo, la uso para revisar los deberes a mi hijo.
Javier
usuario de Android
Sinceramente me ha salvado los estudios. Recomiendo la aplicación 100%.
Erick
usuario de Android
Me me encanta esta app, todo lo que tiene es de calidad ya que antes de ser publicado es revisado por un equipo de profesionales. Me ha ido genial esta aplicación ya que gracias a ella puedo estudiar mucho mejor, sin tener que agobiarme porque mi profesor no ha hecho teoría o porque no entiendo su teoría. Le doy un 10 de 10!
Mar
usuaria de iOS

Acceso a todos los documentos
Mejora tus notas
Únete a millones de estudiantes
Al registrarte aceptas las Condiciones del servicio y la Política de privacidad.

Acceso a todos los documentos
Mejora tus notas
Únete a millones de estudiantes
Al registrarte aceptas las Condiciones del servicio y la Política de privacidad.

Acceso a todos los documentos
Mejora tus notas
Únete a millones de estudiantes
Al registrarte aceptas las Condiciones del servicio y la Política de privacidad.

Acceso a todos los documentos
Mejora tus notas
Únete a millones de estudiantes
Al registrarte aceptas las Condiciones del servicio y la Política de privacidad.

Acceso a todos los documentos
Mejora tus notas
Únete a millones de estudiantes
Al registrarte aceptas las Condiciones del servicio y la Política de privacidad.

Acceso a todos los documentos
Mejora tus notas
Únete a millones de estudiantes
Al registrarte aceptas las Condiciones del servicio y la Política de privacidad.

Acceso a todos los documentos
Mejora tus notas
Únete a millones de estudiantes
Al registrarte aceptas las Condiciones del servicio y la Política de privacidad.

Acceso a todos los documentos
Mejora tus notas
Únete a millones de estudiantes
Al registrarte aceptas las Condiciones del servicio y la Política de privacidad.

Acceso a todos los documentos
Mejora tus notas
Únete a millones de estudiantes
Al registrarte aceptas las Condiciones del servicio y la Política de privacidad.
Acceso a todos los documentos
Mejora tus notas
Únete a millones de estudiantes
Al registrarte aceptas las Condiciones del servicio y la Política de privacidad.
Nuestro compañero de IA está específicamente adaptado a las necesidades de los estudiantes. Basándonos en los millones de contenidos que tenemos en la plataforma, podemos dar a los estudiantes respuestas realmente significativas y relevantes. Pero no se trata solo de respuestas, el compañero también guía a los estudiantes a través de sus retos de aprendizaje diarios, con planes de aprendizaje personalizados, cuestionarios o contenidos en el chat y una personalización del 100% basada en las habilidades y el desarrollo de los estudiantes.
Puedes descargar la app en Google Play Store y Apple App Store.
Sí, tienes acceso gratuito a los contenidos de la aplicación y a nuestro compañero de IA. Para desbloquear determinadas funciones de la aplicación, puedes adquirir Knowunity Pro.
87
Herramientas Inteligentes NUEVO
Transforma estos apuntes en: ✓ 50+ Preguntas de Práctica ✓ Flashcards Interactivas ✓ Examen Completo de Práctica ✓ Esquemas de Ensayo
Los tejidos del cuerpo
Tejido epitelial, conectivo, muscular y nervioso
Apuntes sobre los tejidos del cuerpo humano con fotos y aclaraciones
Biologia 3° ESO
App Store
Google Play
La app es muy fácil de usar y está muy bien diseñada. Hasta ahora he encontrado todo lo que estaba buscando y he podido aprender mucho de las presentaciones. Definitivamente utilizaré la aplicación para un examen de clase. Y, por supuesto, también me sirve mucho de inspiración.
Pablo
usuario de iOS
Esta app es realmente genial. Hay tantos apuntes de clase y ayuda [...]. Tengo problemas con matemáticas, por ejemplo, y la aplicación tiene muchas opciones de ayuda. Gracias a Knowunity, he mejorado en mates. Se la recomiendo a todo el mundo.
Elena
usuaria de Android
Vaya, estoy realmente sorprendida. Acabo de probar la app porque la he visto anunciada muchas veces y me he quedado absolutamente alucinada. Esta app es LA AYUDA que quieres para el insti y, sobre todo, ofrece muchísimas cosas, como ejercicios y hojas informativas, que a mí personalmente me han sido MUY útiles.
Ana
usuaria de iOS
Está app es muy buena, tiene apuntes que son de mucha ayuda y su IA es fantástica, te explica a la perfección y muy fácil de entender lo que necesites, te ayuda con los deberes, te hace esquemas... en definitiva es una muy buena opción!
Sophia
usuario de Android
Me encanta!!! Me resuelve todo con detalle y me da la explicación correcta. Tiene un montón de funciones, ami me ha ido genial!! Os la recomiendo!!!
Marta
usuaria de Android
La uso casi diariamente, sirve para todas las asignaturas. Yo, por ejemplo la utilizo más en inglés porque se me da bastante mal, ¡Todas las respuestas están correctas! Consta con personas reales que suben sus apuntes y IA para que puedas hacer los deberes muchísimo más fácil, la recomiendo.
Izan
usuario de iOS
¡La app es buenísima! Sólo tengo que introducir el tema en la barra de búsqueda y recibo la respuesta muy rápido. No tengo que ver 10 vídeos de YouTube para entender algo, así que me ahorro tiempo. ¡Muy recomendable!
Sara
usuaria de Android
En el instituto era muy malo en matemáticas, pero gracias a la app, ahora saco mejores notas. Os agradezco mucho que hayáis creado la aplicación.
Roberto
usuario de Android
Esto no es como Chatgpt, es MUCHISMO MEJOR, te hace unos resúmenes espectaculares y gracias a esta app pase de sacar 5-6 a sacar 8-9.
Julyana
usuaria de Android
Es la mejor aplicación del mundo, la uso para revisar los deberes a mi hijo.
Javier
usuario de Android
Sinceramente me ha salvado los estudios. Recomiendo la aplicación 100%.
Erick
usuario de Android
Me me encanta esta app, todo lo que tiene es de calidad ya que antes de ser publicado es revisado por un equipo de profesionales. Me ha ido genial esta aplicación ya que gracias a ella puedo estudiar mucho mejor, sin tener que agobiarme porque mi profesor no ha hecho teoría o porque no entiendo su teoría. Le doy un 10 de 10!
Mar
usuaria de iOS
La app es muy fácil de usar y está muy bien diseñada. Hasta ahora he encontrado todo lo que estaba buscando y he podido aprender mucho de las presentaciones. Definitivamente utilizaré la aplicación para un examen de clase. Y, por supuesto, también me sirve mucho de inspiración.
Pablo
usuario de iOS
Esta app es realmente genial. Hay tantos apuntes de clase y ayuda [...]. Tengo problemas con matemáticas, por ejemplo, y la aplicación tiene muchas opciones de ayuda. Gracias a Knowunity, he mejorado en mates. Se la recomiendo a todo el mundo.
Elena
usuaria de Android
Vaya, estoy realmente sorprendida. Acabo de probar la app porque la he visto anunciada muchas veces y me he quedado absolutamente alucinada. Esta app es LA AYUDA que quieres para el insti y, sobre todo, ofrece muchísimas cosas, como ejercicios y hojas informativas, que a mí personalmente me han sido MUY útiles.
Ana
usuaria de iOS
Está app es muy buena, tiene apuntes que son de mucha ayuda y su IA es fantástica, te explica a la perfección y muy fácil de entender lo que necesites, te ayuda con los deberes, te hace esquemas... en definitiva es una muy buena opción!
Sophia
usuario de Android
Me encanta!!! Me resuelve todo con detalle y me da la explicación correcta. Tiene un montón de funciones, ami me ha ido genial!! Os la recomiendo!!!
Marta
usuaria de Android
La uso casi diariamente, sirve para todas las asignaturas. Yo, por ejemplo la utilizo más en inglés porque se me da bastante mal, ¡Todas las respuestas están correctas! Consta con personas reales que suben sus apuntes y IA para que puedas hacer los deberes muchísimo más fácil, la recomiendo.
Izan
usuario de iOS
¡La app es buenísima! Sólo tengo que introducir el tema en la barra de búsqueda y recibo la respuesta muy rápido. No tengo que ver 10 vídeos de YouTube para entender algo, así que me ahorro tiempo. ¡Muy recomendable!
Sara
usuaria de Android
En el instituto era muy malo en matemáticas, pero gracias a la app, ahora saco mejores notas. Os agradezco mucho que hayáis creado la aplicación.
Roberto
usuario de Android
Esto no es como Chatgpt, es MUCHISMO MEJOR, te hace unos resúmenes espectaculares y gracias a esta app pase de sacar 5-6 a sacar 8-9.
Julyana
usuaria de Android
Es la mejor aplicación del mundo, la uso para revisar los deberes a mi hijo.
Javier
usuario de Android
Sinceramente me ha salvado los estudios. Recomiendo la aplicación 100%.
Erick
usuario de Android
Me me encanta esta app, todo lo que tiene es de calidad ya que antes de ser publicado es revisado por un equipo de profesionales. Me ha ido genial esta aplicación ya que gracias a ella puedo estudiar mucho mejor, sin tener que agobiarme porque mi profesor no ha hecho teoría o porque no entiendo su teoría. Le doy un 10 de 10!
Mar
usuaria de iOS